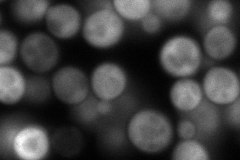
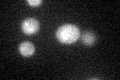
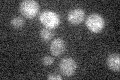

View description
Alpha-isopropylmalate synthase (2-isopropylmalate synthase); the main isozyme responsible for the first step in the leucine biosynthesis pathway
Localization:
Intensity:
Fold change:
Significance:
-
C’ GFP library in SD

below threshold15.74 -
N' NOP1pr-GFP in SD

mitochondria216.406 -
N' TEF2pr-mCherry in SD

mitochondria378.057 -
N' NATIVEpr-GFP in SD
cytosol182.451 -
N' TEF2pr-VC and Cyto-VN in SD

#N/A0 -
C’ GFP library in SD+DTT
cytosol17.011.08No -
C’ GFP library in SD+H2O2

cytosol15.951.01No -
C’ GFP library in Starvation Media
cytosol14.810.94No -
C’ GFP library on the background of Pup2-DaMP

below threshold -
C’ GFP library on the background of CCT mutant

below threshold17.95141.13991No
